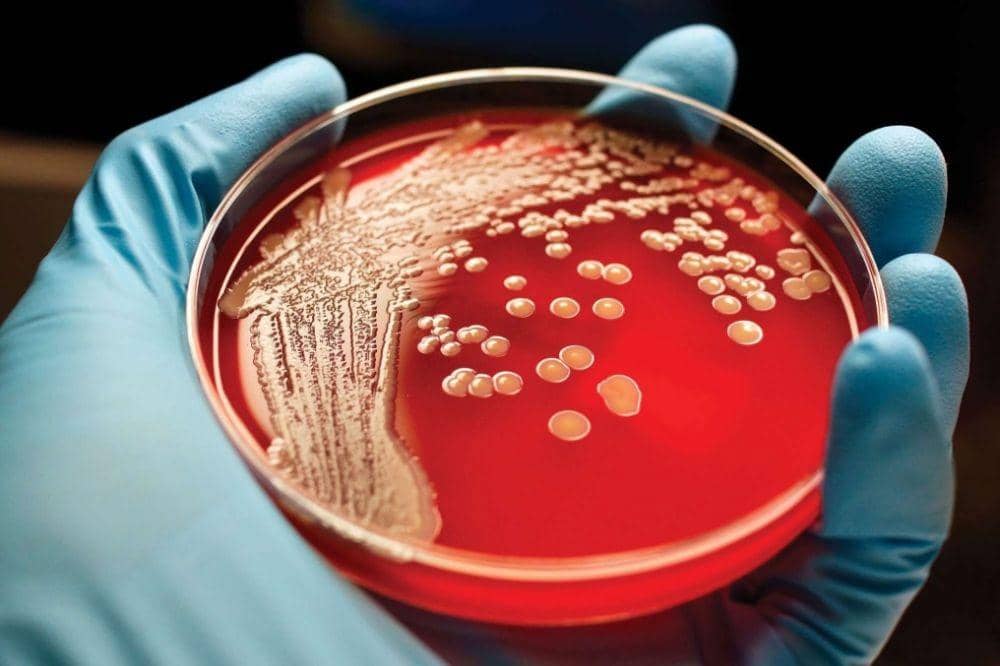
meconferences.com

5 Fakta tentang Kanker Darah, Penyakit yang Diderita Ani Yudhoyono

Kabar duka datang dari Ibu Kristiani Herawati atau akrab dipanggil Ani Yudhoyono, istri Presiden keenam RI, Susilo Bambang Yudhoyono. Pada 12 Februari 2019 di Singapura, Susilo Bambang Yudhoyono menyampaikan bahwa istrinya didiagnosis mengidap kanker darah.
Pada hari ini, Sabtu (1/6), Ibu Ani Yudhoyono harus berpulang ke hadapan Yang Maha Kuasa karena kanker darahnya yang diderita. Lantas, apa itu kanker darah? Dilansir dari Hermatology dan WebMD, berikut fakta tentang kanker darah.
1. Kanker darah memengaruhi produksi dan fungsi sel darah
Sebagian besar kanker darah bermula di sumsum tulang tempat darah diproduksi. Sel induk di sumsum tulang akan matang dan berkembang menjadi tiga jenis sel darah, yaitu sel darah merah, sel darah putih, dan trombosit. Sementara, sebagian besar kanker darah disebabkan terganggunya sel darah normal akibat pertumbuhan tak terkontrol dari sel darah abnormal.
Sel-sel darah yang abnormal atau sel-sel kanker mencegah darah melakukan fungsinya, salah satunya melawan infeksi atau mencegah pendarahan yang serius. Jenis kanker darah sendiri terbagi menjadi tiga, yaitu leukemia, limfoma, dan myeloma.
2. Leukemia, kanker yang ditemukan dalam darah dan sumsum tulang

Kanker ini disebabkan produksi cepat dari sel-sel darah putih abnormal. Tingginya jumlah sel darah putih yang abnormal tidak mampu melawan infeksi sehingga mereka merusak kemampuan sumsum tulang untuk menghasilkan sel darah merah dan trombosit.
3. Limfoma, jenis kanker darah yang mempengaruhi sistem limfatik

Sistem limfatik berfungsi menghilangkan kelebihan cairan dari tubuh Anda dan menghasilkan sel-sel kekebalan. Limfosit adalah jenis sel darah putih yang melawan infeksi. Limfosit abnormal menjadi sel limfoma yang berkembang biak dan berkumpul di kelenjar getah bening dan jaringan lainnya. Seiring berjalannya waktu, sel-sel kanker ini merusak sistem kekebalan tubuh penderitanya.
4. Myeloma, kanker sel-sel plasma

Sel plasma adalah sel darah putih yang menghasilkan antibodi penangkal penyakit dan infeksi dalam tubuh manusia. Sel-sel myeloma mencegah produksi antibodi yang normal sehingga membuat sistem kekebalan tubuh penderitanya melemah dan rentan terhadap infeksi.
5. Kanker darah memang bisa berbeda-beda, namun masing-masing memiliki gejala dan tanda umum yang serupa

Ada banyak gejala kanker darah, antara lain batuk atau nyeri dada; demam atau kedinginan; infeksi yang terus-menerus; kulit gatal atau ruam; kehilangan nafsu makan dan mual; berkeringat di malam hari; kelemahan dan kelelahan yang terus-menerus; sesak napas; pembengkakan; munculnya kelenjar getah bening tanpa rasa sakit di leher, ketiak, atau selangkangan.
Itu tadi fakta-fakta tentang kanker darah yang perlu kamu tahu. Semoga keluarga yang ditinggalkan Ibu Ani Yudhoyono diberikan kekuatan dan kesabaran.



























![[QUIZ] Siapakah kamu sebenarnya?](https://image.rujakcingur.com/post/20250611/1401x788-Screen-Shot-2015-01-18-at-8.29.01-AM_zpsaxbn64rp.png)

.png)














